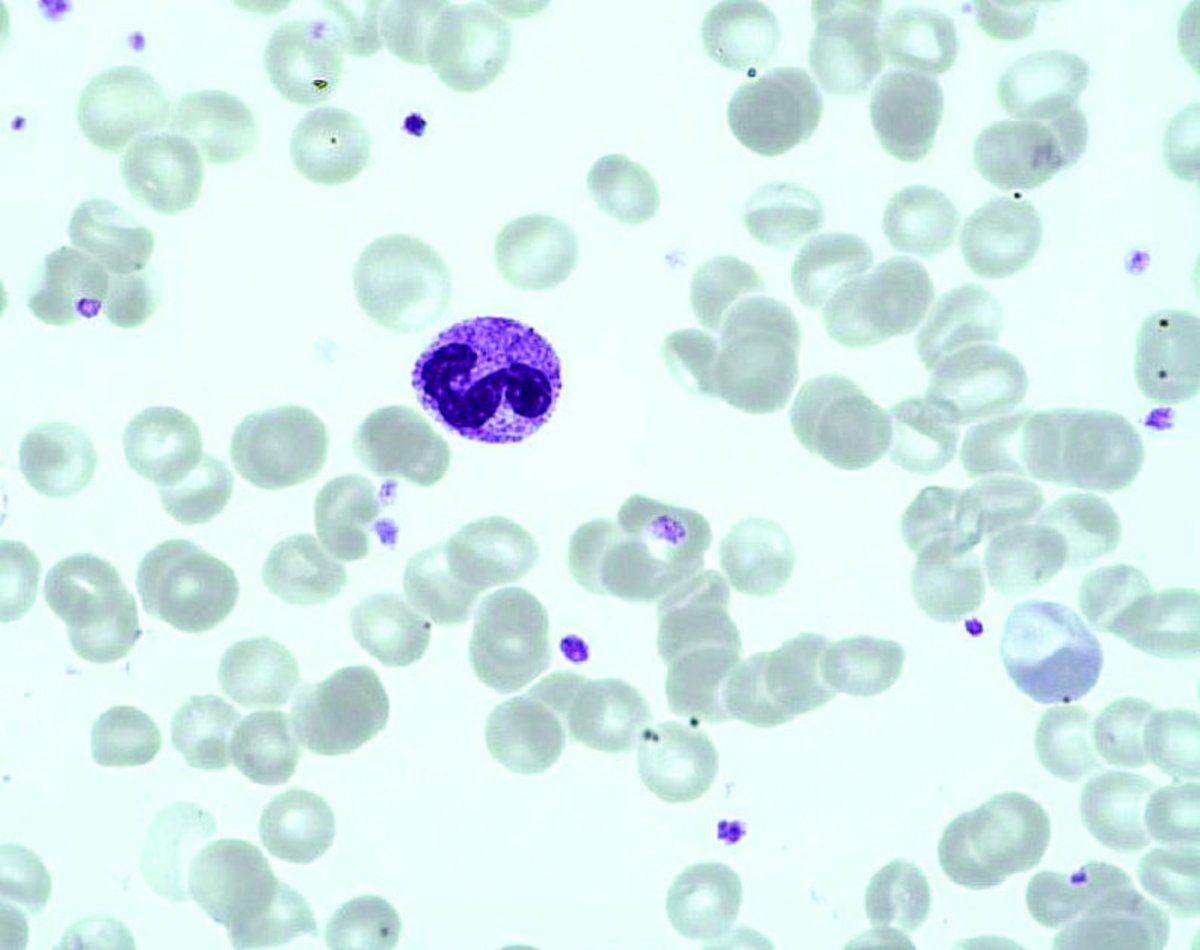
Neutrophil polymorphonuclear Neutrophil polymorphonuclear

Neutrophil polymorphonuclear
- Size : Medium, 12-15 µm
- N/C ratio= Medium, 0.4
- Cytoplasm
- Extension : Abundant
- Basophilia : Absent
- Number of granules : Numerous
- Color of granules : Brown = neutrophil
- Membrane : Regular
- Nucleus
- Situation : Central
- Chromatin : Dense
- Nucleoli : Absent
- Membrane : Regular
- Normal values : 1.5 - 7 x 10(9)/L
- Description / Pathology :
Round cell of average size, segmented nucleus (2-5 lobes connected by chromatin filaments), with a condensed chromatin, no nucleolus, unstained cytoplasm covered with fine neutrophil granules.
PNN Leukocytosis: Reactive (in case of infections + + +), Granulocytic regeneration, Treatment with corticosteroid drugs, Tobacco consumption.
Pregnancy.
Very rare neutrophil leukemia (diagnosis of exclusion)